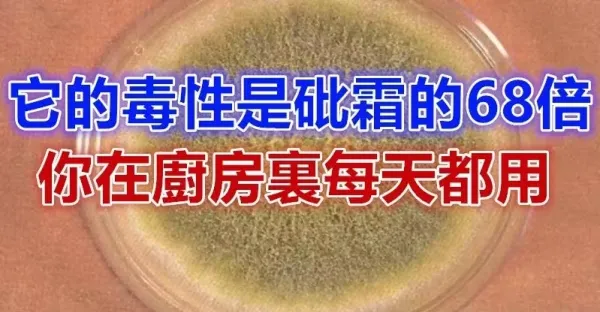

滿素荷 • 660次觀看

滿素荷 • 550次觀看

娃娃魚 • 250次觀看

喜歡你 • 90次觀看

喜歡你 • 130次觀看

甘祥韻 • 1K次觀看

滿素荷 • 380次觀看

滿素荷 • 320次觀看

滿素荷 • 640次觀看

滿素荷 • 150次觀看

甘祥韻 • 6K次觀看

甘祥韻 • 2K次觀看

甘祥韻 • 2K次觀看

甘祥韻 • 1K次觀看

甘祥韻 • 1K次觀看

滿素荷 • 690次觀看

滿素荷 • 320次觀看

滿素荷 • 710次觀看

滿素荷 • 570次觀看

滿素荷 • 640次觀看

劉奇奇 • 110次觀看

劉奇奇 • 2K次觀看

劉奇奇 • 180次觀看

劉奇奇 • 330次觀看